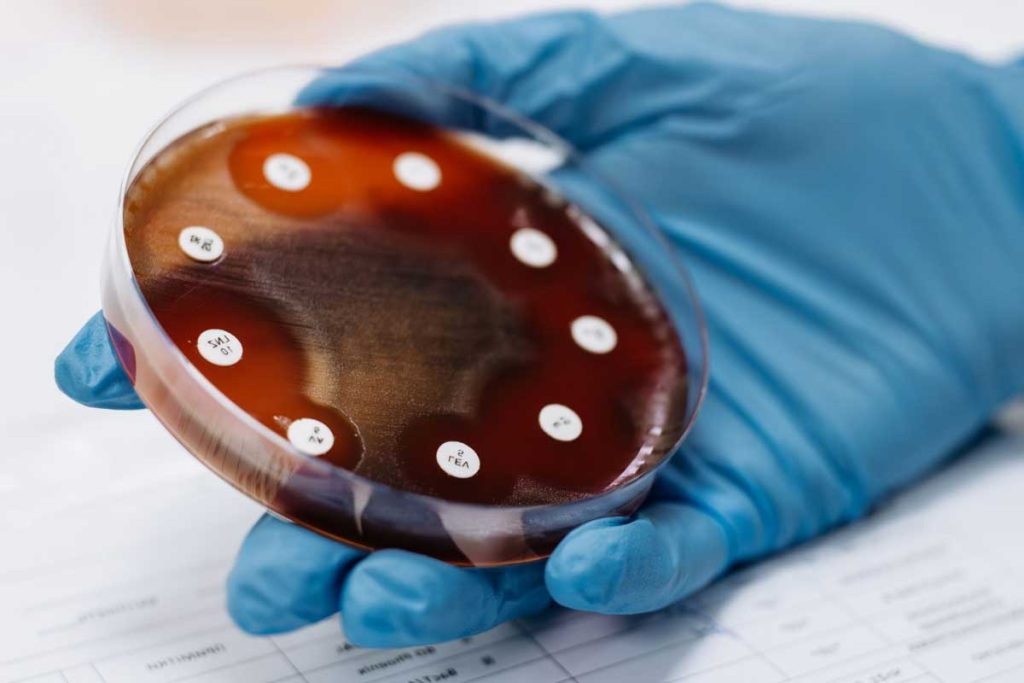

La panspermie, une hypothèse selon laquelle la vie sur Terre serait d’origine extraterrestre, n’a jamais été prouvée. Toutefois, des études comme celle publiée dans la revue Nature par l’équipe du professeur Yasuhiro Oba et qui porte sur des traces de cytosine et de thymine sur des météorites carbonées, confortent cette théorie. Par ailleurs, les découvertes de bactéries inconnues dans l’espace constituent des éléments qui ne permettent pas d’écarter totalement cette hypothèse. En 2023, des scientifiques chinois ont prélevé un micro-organisme jamais répertorié sur Terre dans la station spatiale Tiangong, lors de la mission Shenzhou 15. Baptisé Niallia tiangongensis, il possède des caractéristiques génétiques uniques et est capable de survivre dans des conditions extrêmes. Mais est-ce réellement une forme de vie extraterrestre ? Découverte !
Une bactérie du genre Niallia
Envoyée sur Terre au mois de juin 2023, Niallia tiangongensis a été analysée par des scientifiques du Shenzhou Space Biotechnology Group et de l’Institut d’ingénierie des systèmes spatiaux de Pékin. Les résultats ont montré que ce micro-organisme prélevé dans la station spatiale chinoise est une variante d’une bactérie aérobie déjà répertoriée sur Terre, appelée Niallia circulans. En raison de ses nombreuses similarités avec cette dernière, les chercheurs estiment qu’il n’est pas réellement d’origine extraterrestre. Toutefois, il n’est pas encore possible d’affirmer s’il est le résultat de la mutation spatiale d’un organisme présent sur les équipements des astronautes. Il est possible que ce soit une évolution entraînée par l’environnement dans lequel il a évolué durant le voyage en orbite.


Des capacités exceptionnelles
Bien qu’elle ressemble à une souche de bactérie présente sur Terre, Niallia tiangongensis est différente sur de nombreux points. Les analyses réalisées par l’équipe du Shenzhou Space Biotechnology Group et l’Institut d’ingénierie des systèmes spatiaux de Pékin ont permis d’identifier des différences au niveau de deux protéines. Ce qui explique ses capacités uniques. D’une part, ces macromolécules permettent au micro-organisme de résister au stress cellulaire, un déséquilibre pouvant engendrer de graves détériorations au niveau des tissus, mais également à la microgravité. D’autre part, ils offrent à la bactérie la capacité de réparer les dommages liés à une exposition prolongée à de fortes radiations. Selon les scientifiques en charge de l’étude, Niallia tiangongensis a développé des mécanismes spécifiques pour garantir sa survie dans l’environnement spatial.
Un micro-organisme qui peut être utile lors des explorations spatiales
Le micro-organisme découvert par les astronautes chinois peut survivre dans des conditions extrêmes, mais également métaboliser certains composés organiques. Grâce à cette capacité à décomposer les déchets, il peut être utilisé dans la conception de systèmes de recyclage biologiques installés dans les stations spatiales. D’un autre côté, sa résistance aux rayonnements cosmiques se présente comme une solution pour mettre au point des boucliers protégeant les astronautes lors des voyages spatiaux.
Chinese scientists have discovered a new microbe that developed on board the county’s Tiangong space station, according to a new study. The strain, officially named niallia tiangongensis, is a new variant of a previously known terrestrial bacteria and was found on a cabin in the… pic.twitter.com/FpJZJemNei
— China Perspective (@China_Fact) May 20, 2025
À noter que des prélèvements microbiens sont régulièrement effectués pour identifier et analyser les micro-organismes présents dans les stations spatiales, et ce n’est pas la première fois qu’un équipage découvre une nouvelle souche. En effet, avant Niallia tiangongensis, une vingtaine de bactéries uniques ont été prélevées dans l’ISS (Station spatiale internationale), dont une qui permettrait aux astronautes de cultiver des plantes dans des environnements spécifiques, comme celui de Mars. L’univers recèle encore une multitude de choses à découvrir, alors que nous ne sommes qu’aux prémices de l’exploration spatiale, quelles seront nos prochaines découvertes ? Je vous invite à nous donner votre avis, vos remarques ou nous remonter une erreur dans le texte, cliquez ici pour publier un commentaire .